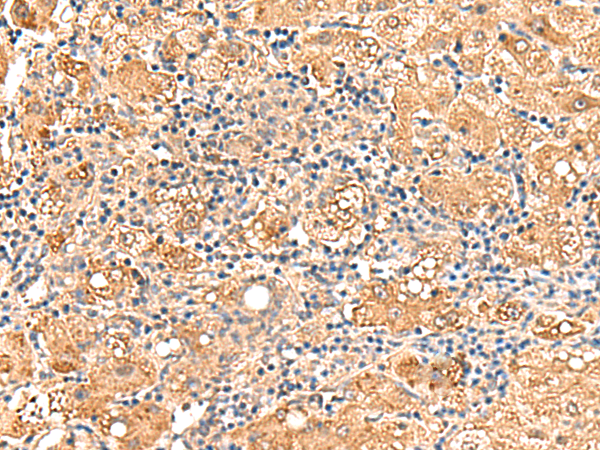
一抗

Background:
The protein encoded by this gene catalyzes the conversion of sn-glycerol 3-phosphate to glycerone phosphate. The encoded protein is found in the cytoplasm, associated with the plasma membrane, where it binds the sodium channel, voltage-gated, type V, alpha subunit (SCN5A). Defects in this gene are a cause of Brugada syndrome type 2 (BRS2) as well as sudden infant death syndrome (SIDS).
Applications:
ELISA, IHC
Name of antibody:
GPD1L
Immunogen:
Fusion protein of human GPD1L
Full name:
glycerol-3-phosphate dehydrogenase 1 like
Synonyms:
GPD1-L
SwissProt:
Q8N335
ELISA Recommended dilution:
5000-10000
IHC positive control:
Human tonsil and Human liver cancer
IHC Recommend dilution:
50-300


 購物車
購物車 幫助
幫助
 021-54845833/15800441009
021-54845833/15800441009